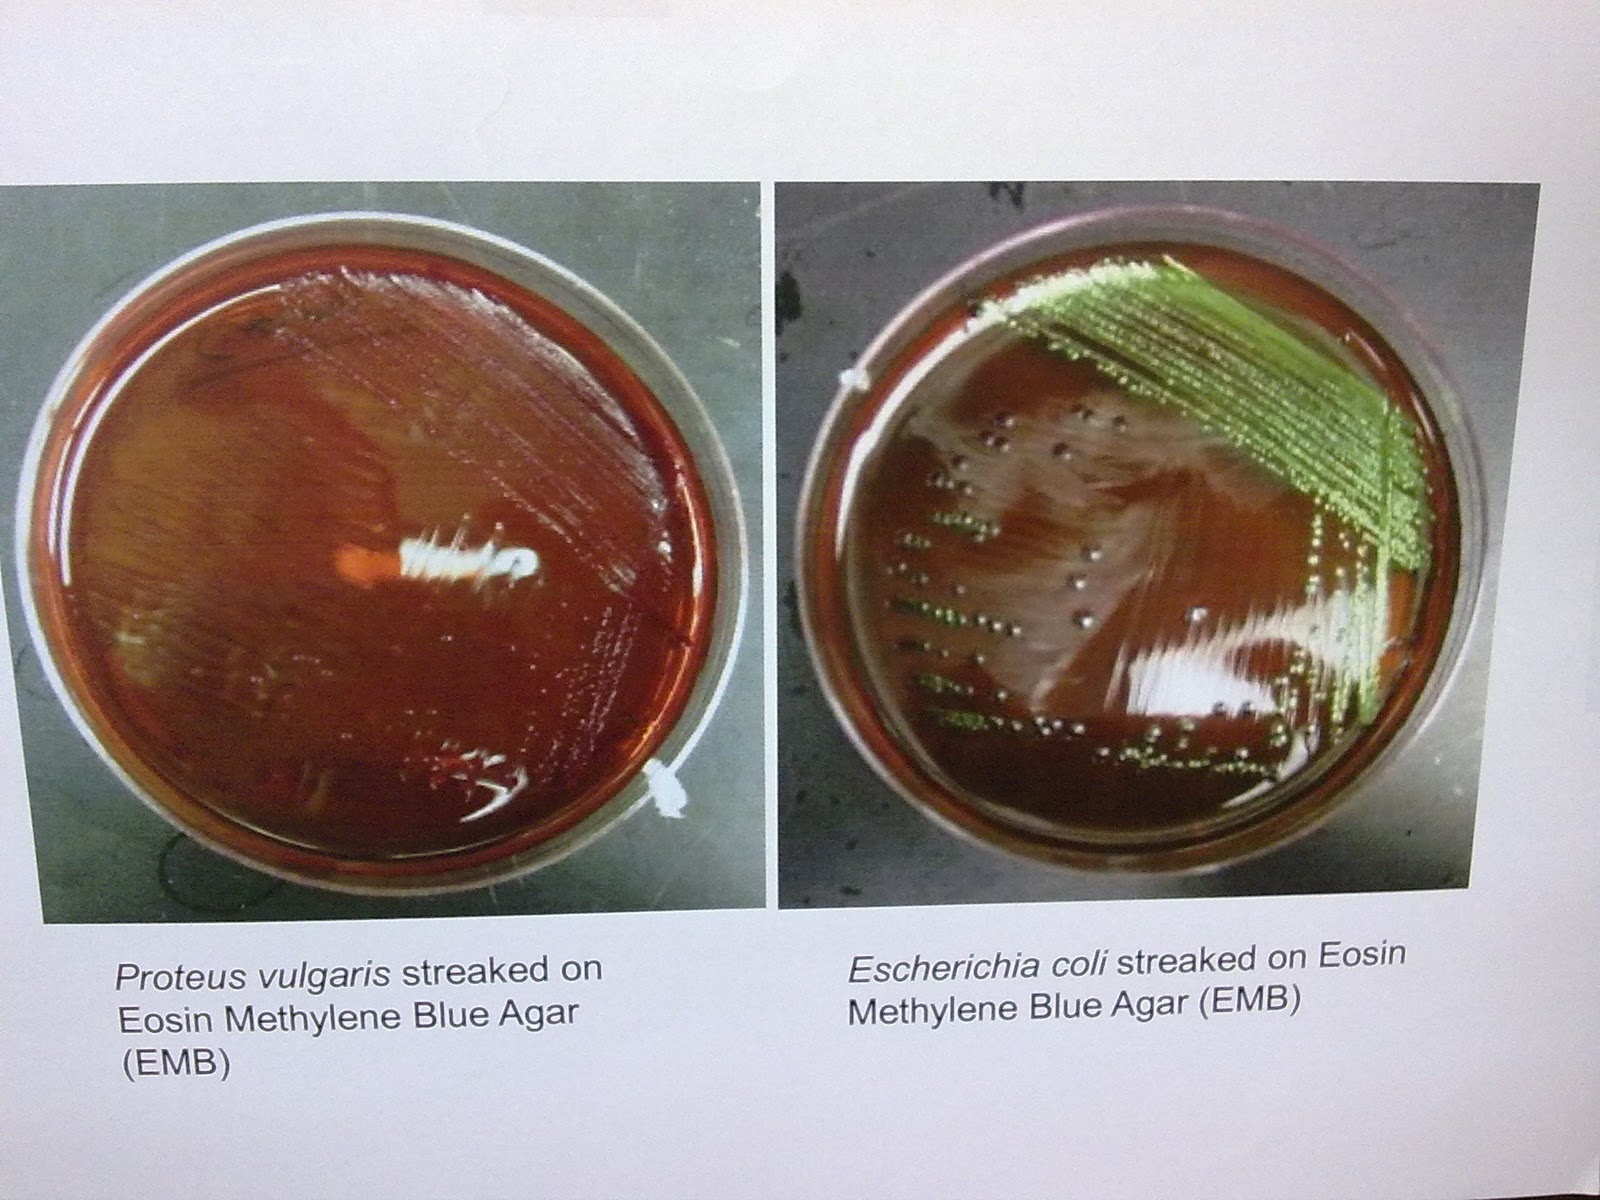

Протей в кале
What is a masking
Здесь не устроишься
Проекты комнат для разнополых детей
Сравнение карт городов
Почему прощать прощение
Как устранить течь трубы канализации
Задний стоп пежо 307
O hara ул дружбы 23 корп 1
Зачем весной все цветет а осенью увядает
Отсутствие пальцев как называется
Клип песни brother
Гранола при похудении
Строительный колледж на карте
Протей в кале 116 фотографий